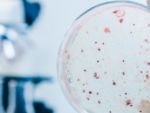
Böbrek kanserinde artış var

SAĞLIK
SON EKLENEN GALERİLER
Çocuk ateşlenince ne yapılmalı?Ateşin bir hastalık değil hastalık habercisi olduğu uzmanlar tarafından belirtildi.
Aksaray’da Yılın Doktoru SeçildiAksaray Devlet Hastanesi Kardiyoloji Uzmanı Dr. Sinan İnci, Sağlık Bakanlığı tarafından Aksaray’da yılın doktoru seçildi.14 Mart Tıp Bayramı nedeniyle Sağlık Bakanlığı’nca 81 ilden seçilen yılın dokto...
Böbrek yetmezliğine çörek otu yağıUzmanlar, çörek otu yağını bütün böbrek yetmezliği hastalarına tavsiye etti.
Beray Güler yardım bekliyorAkciğer kanserine yakalanan Beray Güler (5), hayırseverlerin yardımını bekliyor. Ankara'da tedavi gören minik Beray, tedaviye de olumlu cevap veriyor11 Mart 2015 Çarşamba 23:25
Tatlı krizine karşı bunları tüketinUzmanlar çikolata ihtiyacının giderilmesi için su içmeyi ve meyve tüketmeyi öneriyor.
Yine mide küçültme ameliyatı, yine ölüm!Balıkesir’in Ayvalık ilçesinde 2 çocuk annesi genç kadın, geçirdiği mide küçültme ameliyatının ardından rahatsızlanarak hayatını kaybetti.
Kızılay Kan Toplama Aracı Aksaray’daKızılay’ın Kayseri Kan Bağışı Bölge Müdürlüğü’ne bağlı gezici kan toplama aracı Aksaray’a geldi.Gezici kan bağışı aracının Mart ayı sonuna kadar kent meydanında olacağını ifade eden Kan Toplama Aracı...- Konya’da Yirmi Bin Öğrenci ‘Ben de Fırçalıyorum’ Diyecek…..
- Türk doktor tıp literatürüne girdi!
- Konya İl Sağlık Müdürü Küçükkendirci Hastaları Evlerinde Ziyaret Etti
- Yüzdeki Sinir Ağrılarına Mikrocerrahi Yöntemle Tedavi!
- Konya'nın İlçelerine sağlıklı su geliyor
- Obezite dünyada yayılıyor
- Vitamin kaybına karşı tüketin
- Selçuklu'ya Modern Aile Sağlığı Ve Ağız Diş Sağlığı Merkezi
- Elektriksiz sağlık ocağında sağlık hizmeti
- Öğrenciler doya doya süt içicek
- İdrar kaçırıyorsanız dikkat!
- Aksaray Devlet Hastanesi'ne Endokrinoloji Uzmanı atandı
- Başkan Kale'den hasta ziyareti
- Kadınların evlilikteki kabusu: Vajinismus
- Doktor, Fidan Dikerek Mesleki Yaşamına Veda Etti
- Çekirdek gibi Toprak Yiyen Kadınlara Kanser Taraması
- İşte kıırlığın en büyük nedeni!
- Saat ve yüzüğünüz aşırı sıkmaya başladıysa dikkat
- Mezar Taşlarıyla O Hastalıktan Ölenlerin Sayısını Belirleyecek
- Aileler Toplu Sünnetleri Tercih Etmemeli
Tüm Hakları Saklıdır © 2013 Güvenli Haber | İzinsiz ve kaynak gösterilmeden yayınlanamaz.
Tel : 05343258300
Tel : 05343258300